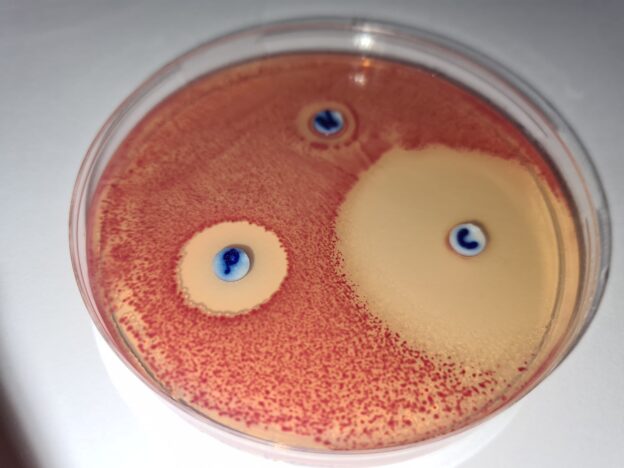

ANTIBIOGRAMA MUELLER HINTON AGAR ES EL MEDIO DE CULTIVO ESTÁNDAR PARA DETECTAR A QUÉ ANTIBIÓTICOS ES SUSCEPTIBLE UN MICROORGANISMO
Antibiogramas (cálculo de la Concentración Mínima Inhibitoria de antibióticos para la cepa problema). Base para agar sangre y detección de Neisseria.
COMPOSICIÓN
- Infusión de carne 2,0 g
- Peptona de caseina 17,5 g
- Almidón 1,5 g
- Agar agar 17,0 g
(Fórmula por litro)
pH final: 7,4 ± 0,2
PREPARACIÓN
Disolver 38 g de medio en 1 litro de agua destilada.
Calentar hasta ebullición, agitando para su disolución.
Autoclavar a 121 ºC durante 15 minutos, o bien a 116 ºC durante 15-30 minutos.
PARA USO EXCLUSIVOEN LABORATORIO.
MANTENGA EL BOTE BIEN CERRADO EN LUGAR SECO, FRESCO Y OSCURO. AGITE EL BOTE ANTES DE USAR.
DESHIDRATADO CODIGO: DMT084
CONTROL DE CALIDAD DEL MEDIO
Realizado en nuestro laboratorio; es prudente repetirlo en su laboratorio siempre que varíen las condiciones (más de 3 meses sin usar, tras desinfectar laboratorio, tras conservar a alta Tª, cuando adquiere aspectos extraños aunque no haya llegado la fecha de caducidad teórica de la etiqueta,…)
DESHIDRATADO: Polvo fino, Beige
PREPARADO: Estéril, Blanquecino
CONTROL DE CRECIMIENTO 24-48 h a 37°C aproximadamente:
- Staphylococcus aureus MKTA 6538P, Correcto.
- Streptococcus pyogenes MKTA 19615, Correcto
- Proteus mirabilis MKTA 14153, Correcto.
- Pseudomonas aeruginosa MKTA 9027, Correcto
- Enterococcus faecalis MKTA 29212, Correcto
PRESENTACIÓN: TUBOS 20 ml, FRASCOS, MEDIO DESHIDRATADO
Medio de referencia para estudiar la sensibilidad bacteriana a los diferentes antibióticos y sulfamidas. BASE de Agar Sangre.
SIEMBRA
Fundir un tubo 20 ml para elaborar una placa o un frasco para elaborar varias. Es contraproducente fundir un frasco varias veces (use tubos 20 ml). No elaborar placas con menos de 4 mm de espesor. Inocular en superficie la solución de la cepa infecciosa con un triángulo de vidrio (VRR154) o asas de Digralsky desechables (VCL155). Dejar secar 10 minutos. Colocar los discos de antibióticos de forma que estén, entre sí y con respecto al borde de la placa, a más de 15 mm. Incubar a 37°C aproximadamente.
Véase también Blood Agar Base: Agar sangre de carnero o de caballo.
INTERPRETACION
Medir los halos de inhibición con un compás. Ver la tabla del MIC (Minimal Inhibitory Concentration) del fabricante de los discos de antibióticos para establecer correlaciones a la hora de decidir qué antibióticos son más recomendables en el tratamiento de la enfermedad.
El usuario es el único responsable de la eliminación de los microorganismos según la legislación medioambiental vigente. Autoclavar antes de desechar a la basura.
Revisado en Julio, 2010
Si desea más información sobre nuestros MUELLER HINTON AGAR rellene nuestro formulario de contacto http://www.medioscultivo.com/contacto . O si lo prefiere póngase en contacto con nosotros a través de nuestro correo electrónico microkit@microkit.es o por teléfono en el nº 91-897 46 16
https://www.microkit.es/fichas/MUELLER-HINTON-AGAR.pdf
MICROKIT ofrece tambien el MH cromogénico, que acelera enormemente Eel tiempo de obtención de resultados del crecimiento de la cepa y la consecuente visión de los halos de inhibición de los discos de antibióticos a los que es susceptible o resistente. Lo que permitirá sin duda un diagnóstico mucho más rápido y salvar muchas más vidas. Solicite la ficha técnica con fotografías en microkit@microkit.es